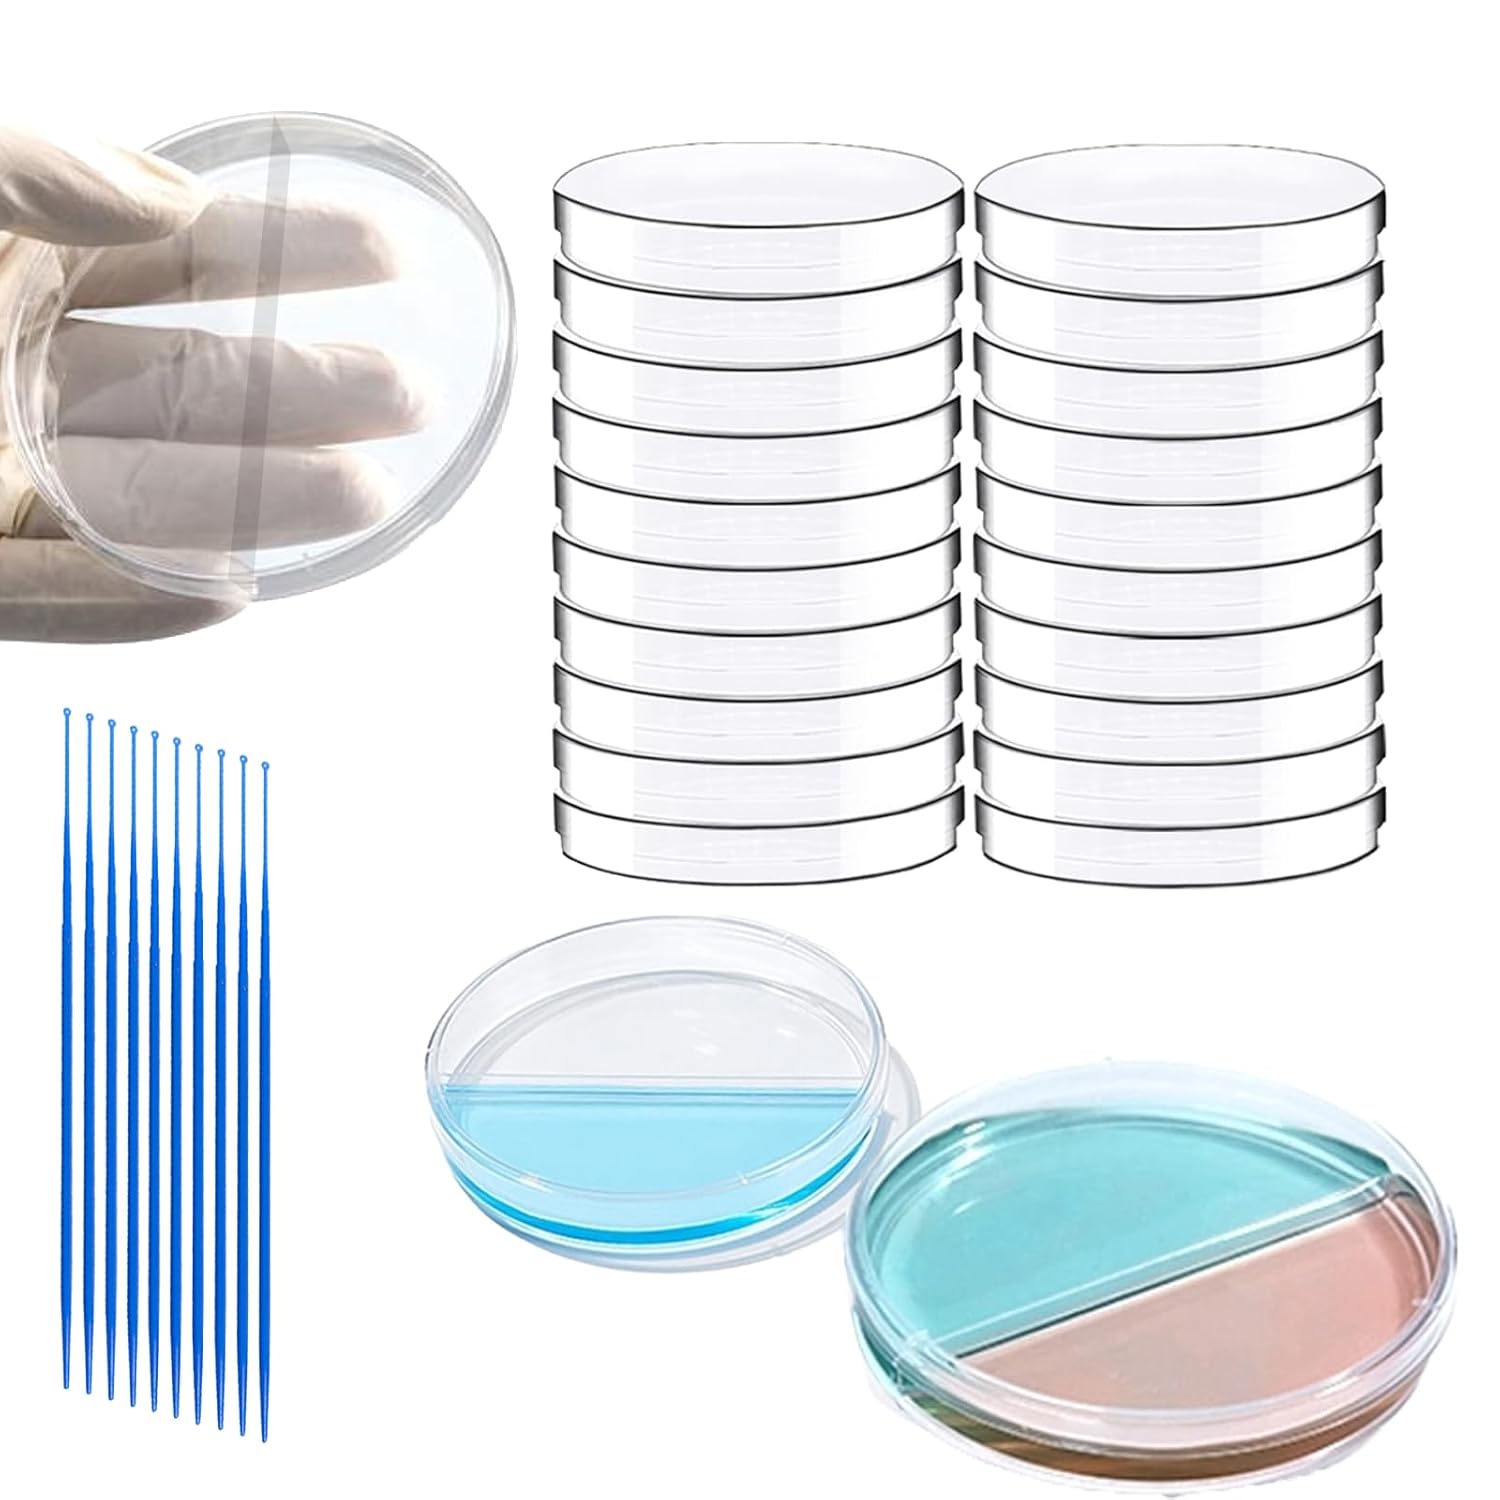
30 PCS 90mm 2 Compartments Plastic Petri Dish with Lids, Sterile with 10PCS 10uL Inoculation Loops

New
Arrivals/Restock
Deckenlampe
 Limited Time Sale
Limited Time SaleUntil the end
14
13
25
$4.75 cheaper than the new price!!
Free shipping for purchases over $99 ( Details )
Free cash-on-delivery fees for purchases over $99
Free cash-on-delivery fees for purchases over $99
See all stores
Please note that the sales price and tax displayed may differ between online and in-store. Also, the product may be out of stock in-store.
New $11.88
Product details
| Management number | 35082539 | Release Date | 2026/01/08 | List Price | $7.13 | Model Number | 35082539 | ||
|---|---|---|---|---|---|---|---|---|---|
| Category | |||||||||
Verkaufe zwei sehr gut erhaltene Lampen. Die Lampen sind über den Lichtschalter in 3 Stufen einstellbar. Größe 22cm x 22cm. Nur Abholung in Emsdetten. Rauchfreier Haushalt. Bei Abnahme von anderen Lampen aus meinen Anzeigen, können wir gerne einen Gesamtpreis vereinbaren.
| Condition | Very good |
| Color | White |
| Category | Home accessories > Lighting > Ceiling lights |
Correction of product information
If you notice any omissions or errors in the product information on this page, please use the correction request form below.
Correction Request Form